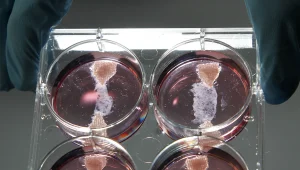
השף הסטון בלומנטל יכין המבורגר שגדל בצלחת מעבדה

אוכל נענע 10


אוכל נענע 10


מדליות זהב לישראל בתחרות בישול עולמית
אוכל נענע 10 | 27.03.2012

צפו: פיסול פרחים באבטיח
אוכל נענע 10 | 25.03.2012

שף בשבוע • יוסי אסרף - מסעדת פורטרהאוס
אוכל נענע 10 | 19.03.2012

מתכון לאמפנדס בתנור
אוכל נענע 10 | 16.03.2012

מתכון לפטריות מטוגנות עם פירה ורוטב שמנת
אוכל נענע 10 | 15.03.2012

שף בשבוע • רועי אגאי - בית היין במעברות
אוכל נענע 10 | 15.03.2012

שיא גינס חדש - אכל 13 טוסטים בדקה
אוכל נענע 10 | 14.03.2012

צפו: אמן סיני מכין סוכריית דרקון מקרמל
אוכל נענע 10 | 23.02.2012

חדש: גלידת שוקולד השחר
אוכל נענע 10 | 13.02.2012

צ'ילי להמונים
אוכל נענע 10 | 08.02.2012

מתכון לשטרודל גבינות וצימוקים
אוכל נענע 10 | 06.02.2012

חורף טעים • 5 המלצות לאירועים קולינריים
אוכל נענע 10 | 05.02.2012

מקשטים את העוגה
אוכל נענע 10 | 31.01.2012

כדאי להכיר • 5 ברי יין מיוחדים
אוכל נענע 10 | 22.01.2012

אפרת אנזל מגישה: סדרת בישול חדשה
אוכל נענע 10 | 17.01.2012

פסטיבל טעמים בעמקים 2012
אוכל נענע 10 | 16.01.2012

סוף שבוע של אוכל חורפי בדיזנגוף סנטר
אוכל נענע 10 | 16.01.2012

אוכלים בחוץ • חדשות קולינריות
אוכל נענע 10 | 06.01.2012

פרי חורף חדש: אבטיח כתום
אוכל נענע 10 | 05.01.2012

לגעת באוכל • חדשות קולינריות
אוכל נענע 10 | 29.12.2011

חנוכה בבית אמא • שף ישראל אהרוני
אוכל נענע 10 | 21.12.2011